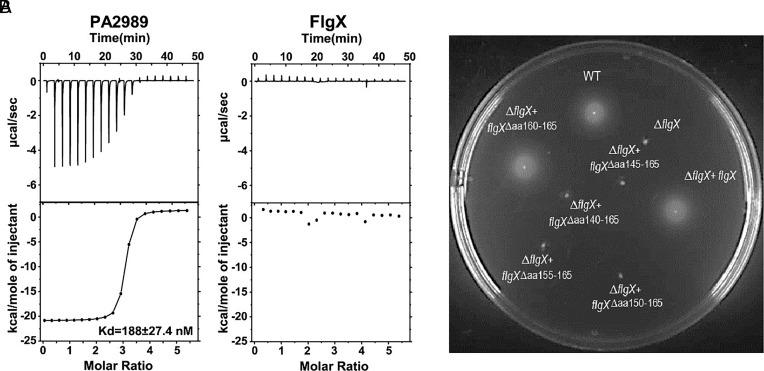
https://cdn.ncbi.nlm.nih.gov/pmc/blobs/8bb3/11725899/5a2152c93181/pnas.2412594121fig02.jpg

四聚体PilZ蛋白稳定复合鞭毛马达中的定子环,并且是[具体生物]运动所必需的。 (注:原文中“in ”后面缺少具体信息)
Tetrameric PilZ protein stabilizes stator ring in complex flagellar motor and is required for motility in .
作者信息
Chen Yuanyuan, Tachiyama Shoichi, Li Yuqian, Feng Xueyin, Zhao Hang, Wu Yanmin, Guo Yu, Lara-Tejero María, Hua Canfeng, Liu Jun, Gao Beile
机构信息
Chinese Academy of Sciences Key Laboratory of Tropical Marine Bio Resources and Ecology, Guangdong Key Laboratory of Marine Materia Medica, Innovation Academy of South China Sea Ecology and Environmental Engineering, Guangdong Provincial Observation and Research Station for Coastal Upwelling Ecosystem, South China Sea Institute of Oceanology, Chinese Academy of Sciences, Guangzhou 511458, China.
Sanya National Marine Ecosystem Research Station, Tropical Marine Biological Research Station in Hainan, Chinese Academy of Sciences, Sanya 572000, China.
出版信息
Proc Natl Acad Sci U S A. 2025 Jan 7;122(1):e2412594121. doi: 10.1073/pnas.2412594121. Epub 2024 Dec 30.
Rotation of the bacterial flagellum, the first identified biological rotary machine, is driven by its stator units. Knowledge gained about the function of stator units has increasingly led to studies of rotary complexes in different cellular pathways. Here, we report that a tetrameric PilZ family protein, FlgX, is a structural component underneath the stator units in the flagellar motor of . FlgX forms a stable tetramer that does not bind cyclic di-GMP (c-di-GMP), unlike other canonical PilZ domain-containing proteins. Cryoelectron tomography and subtomogram averaging of flagellar motors in situ provide evidence that FlgX interacts with each stator unit and plays a critical role in stator ring assembly and stability. Furthermore, FlgX is conserved and was most likely present in the common ancestor of the phylum . Overall, FlgX represents a divergence in function for PilZ superfamily proteins as well as a player in the key stator-rotor interaction of complex flagellar motors.
细菌鞭毛是首个被鉴定出的生物旋转机器,其旋转由定子单元驱动。对定子单元功能的了解越来越多地促使人们对不同细胞途径中的旋转复合体进行研究。在此,我们报告一种四聚体PilZ家族蛋白FlgX是[具体物种]鞭毛马达中定子单元下方的一种结构成分。与其他含典型PilZ结构域的蛋白不同,FlgX形成一种稳定的四聚体,不结合环二鸟苷酸(c-di-GMP)。原位鞭毛马达的冷冻电子断层扫描和亚断层平均分析提供了证据,表明FlgX与每个定子单元相互作用,并在定子环组装和稳定性中起关键作用。此外,FlgX是保守的,很可能存在于[该门生物的]共同祖先中。总体而言,FlgX代表了PilZ超家族蛋白在功能上的一种分化,也是复杂鞭毛马达关键定子-转子相互作用中的一个参与者。